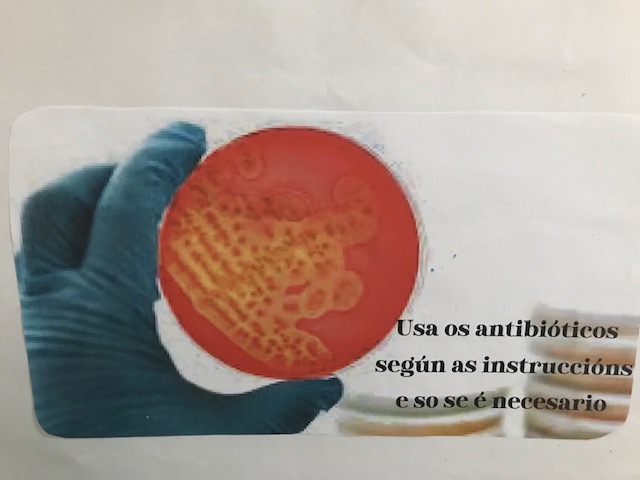

Os alumnos de Bioloxía de 4º da ESO, queremos alertar do perigo das superbacterias. Dedicamos varias sesións a investigar a loita actual entre as superbacterias-antibióticos, como se orixina unha cepa resistente e como colofón final queremos difundir o seguinte lema na semana mundial de concientización ” Prevengamos juntos la resistencia a los antimicrobianos”